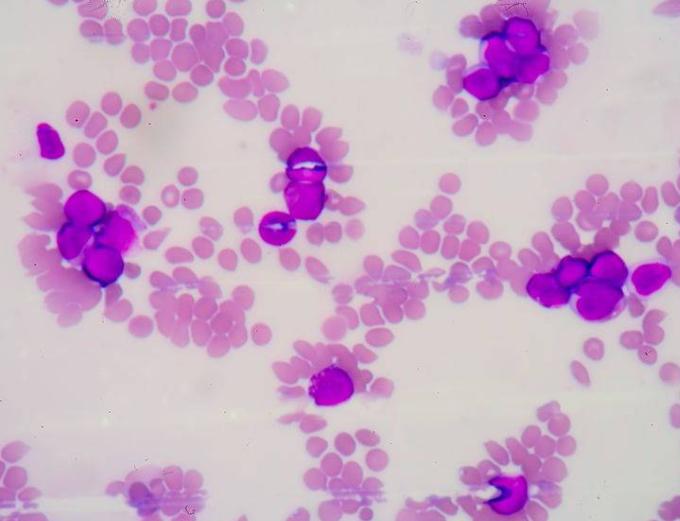
为何确诊肺炎，但白细胞却并不高？赶紧来了解一下

有育儿经验的宝妈们,应该都对“肺炎”疾病不陌生。很多宝宝受免疫力低的影响,很容易出现肺炎疾病。
即便是成年人,在受到细菌、病毒感染之后,也可造成肺炎的病发。比如今年席卷全球的“新型冠状病毒”,在感染后就可导致肺炎出现。

从科学角度来看,肺炎就是肺组织受到病原体感染之后导致的炎性反应。很多人在发生肺炎症状后,就医检查时,都会发现血常规的白细胞有明显升高。
所以就盲目地认为,只要是白细胞升高,才是肺炎的表现,而白细胞轻微升高或正常,则意味着身体健康!
但实际上,这种说法是非常愚昧的;
就如同上文中提到的一般,导致肺炎出现的原因有很多,病菌、细菌、真菌等微生物感染,都可导致肺炎病发,不同病因产生的症状也不相同。
就目前临床掌握的数据来看,最常见的肺炎致病菌为“肺炎链球菌”,是细菌性肺炎的最高发种类,占据全部肺炎患者的50%以上;

这种肺炎链球菌感染引发的炎症,在进行全面检查时,的确会表现出白细胞升高的症状。
但是,临床上也有一部分肺炎,并不属于细菌感染,比如支原体或者是病毒感染等。
这几种病原体导致的肺炎,血常规通常不会有过大的变化,又或者是没有任何升高迹象!
这里要重点提到支原体肺炎,它占据了全部肺炎患者的10%!

支原体肺炎,在冬季病发的比例还会更高。临床研究发现,支原体是介于细菌、病毒之间的微生物,它能够独立生存且具有传染性。
其传染途径就是通过呼吸道传播,而且支原体的易感人群主要就是儿童、青少年、老年人等免疫力低下的人群;
支原体肺炎存在潜伏期,多是在2~3周左右。很多患者都是在去人群密集、异地游玩之后,突然出现了支原体肺炎。
由于其症状和肺炎链球菌引发的肺炎有很多相似之处,比如高热、咳嗽、头痛和乏力等,所以有很多人都会误认为自己是普通的细菌感染;

但是,支原体肺炎也有自身独特点,通常情况下其全身表现较轻,但是呼吸道症状却较严重,特别是咳嗽频繁和剧烈,比细菌性肺炎更加明显。
患者主要表现为阵发性、刺激性呛咳,无痰液排出、痰液中也无明显血丝。在进行x线检查时,能看到阶段性的侵润影!
说了支原体肺炎之后,下面要提到的就是:病毒性肺炎!

病毒性肺炎在感染初期,就会有上呼吸道的症状表现,看起来和普通感冒无异,患者会有咳嗽痰多、打喷嚏、发热等多个症状。
病毒性的肺炎,基本没有特殊针对去除病毒的药物,也就是临床所说的“自限性疾病”,譬如新冠肺炎也属于自限性疾病,在辅助治疗的同时,最需要的就是患者体内的免疫力,需要免疫力将病毒打败;

病毒性肺炎在进行血常规检查时,也没有白细胞增多的表现,有时甚至会有降低表现。同时,中性粒细胞也会有所降低,而单核细胞或淋巴细胞则会升高,这一点和细菌性肺炎完全不同。
所以,在出现肺炎症状之后,医生都会建议患者进行x片、血常规等多方面检查,其目的不是为了赚钱,而是为了确定所患肺炎的性质,并进行针对性的治疗。如果盲目使用药物、滥用抗生素,反而会延误病情诊断和治疗,甚至会给身体造成其他伤害。